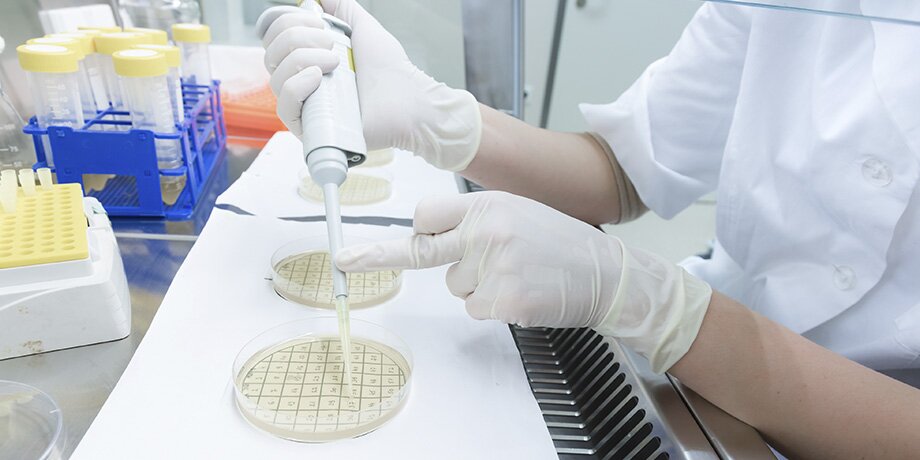

Во льду возрастом 5 000 лет исследователи обнаружили бактерии, устойчивые к антибиотикам "последнего резерва". С подробностями – научный обозреватель Николай Гринько.
Среди потенциальных опасностей, которые могут возникнуть в результате глобального потепления, часто называют таяние вечной мерзлоты и ледников. Кроме того, что это ожидаемо поднимет уровень мирового океана, нас может ждать и еще одна неприятность: в этих льдах заключено огромное количество органики, которая выплеснется в биосферу планеты. Конечно, мамонты и шерстистые носороги не вернутся на просторы тундры, но вот бактерии вполне способны пережить длительную заморозку: их, сохранивших жизнеспособность после тысяч лет холодного сна, уже давно находят и в антарктическом льду, и в почвенной мерзлоте.
Но "долгий лед" встречается не только в континентальных щитах и заполярной почве – есть он и в глубоких пещерах. Недавно микробиологи исследовали образцы из пещеры Скэришоара в Румынии – возраст ледяного массива в ней оценивается примерно в 5 000 лет. Керн был добыт с глубины 25 метров, в нем исследователи и обнаружили бактерии.
Было проведено секвенирование генома, и стало понятно, что найденная бактерия относится к виду Psychrobacter cryohalolentis, который сохраняет жизнеспособность при достаточно низких температурах (от плюс 4 до плюс 15 градусов) и выдерживает высокую концентрацию солей. Psychrobacter – это род, включающий около 50 разных видов бактерий, эволюционно адаптированных к холодным и соленым средам. Они образуют колонии, а некоторые виды способны инфицировать людей и животных.
Продолжив исследование, ученые обнаружили у бактерии больше сотни так называемых генов резистентности. Штамм был протестирован на устойчивость к 28 антибиотикам, которые обычно используются для лечения бактериальных инфекций. Выяснилось, что извлеченная из пещерного льда P. Cryohalolentis успешно сопротивляется 10 современным антибиотикам, среди которых есть даже колистин – антибиотик "последнего резерва". Среди остальных – цефалоспорины третьего поколения, фторхинолоны и рифампицин.
Интернет-издания сразу же подхватили новость, пугая аудиторию очередным концом света: "Древние микробы невозможно победить ни одним современным лекарством!" Впрочем, чуть более серьезные источники информации не ограничились сообщением о резистентности найденной бактерии, разместив и остальные полученные учеными данные. А среди них нашлись и такие: бактерия P. Cryohalolentis показала антимикробный потенциал, подавив рост 14 патогенов, в том числе метициллинрезистентного золотистого стафилококка и синегнойной палочки.
То есть, с одной стороны, опасность существует. Если при таянии льда древние микробы высвободятся, их гены могут распространиться среди современных бактерий, и это усугубит глобальную проблему устойчивости к антибиотикам. Но с другой стороны, они вырабатывают уникальные ферменты и противомикробные соединения, которые могут стать основой для новых антибиотиков, промышленных ферментов и других биотехнологических инноваций.
Вот почему ученые вообще изучают микроорганизмы, пролежавшие в замороженном состоянии тысячи лет. Во-первых, наука и медицина должна быть готова на случай, если тысячелетние бактерии действительно начнут создавать биологическую опасность. А во-вторых, в них могут быть скрыты и механизмы борьбы с этой самой опасностью. Вполне вероятно, что именно древние микробы подскажут нам, как победить болезни, с которыми человечество давно и безуспешно борется.
Хотя…








Собянин поддержал проведение премии в области будущих технологий "Вызов"

Гринько Николай

























